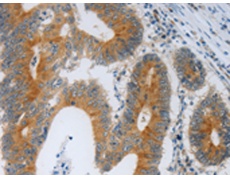
一抗

中文名稱:兔抗F2R多克隆抗體
|
Background: |
Coagulation factor II receptor is a 7-transmembrane receptor involved in the regulation of thrombotic response. Proteolytic cleavage leads to the activation of the receptor. F2R is a G-protein coupled receptor family member. High affinity receptor for activated thrombin coupled to G proteins that stimulate phosphoinositide hydrolysis. May play a role in platelets activation and in vascular development. |
|
Applications: |
ELISA, WB, IHC |
|
Name of antibody: |
F2R |
|
Immunogen: |
Synthetic peptide of human F2R |
|
Full name: |
coagulation factor II (thrombin) receptor |
|
Synonyms: |
TR, HTR, CF2R, PAR1, PAR-1 |
|
SwissProt: |
P25116 |
|
ELISA Recommended dilution: |
1000-5000 |
|
IHC positive control: |
Human colon cancer and Human ovarian cancer |
|
IHC Recommend dilution: |
50-200 |
|
WB Predicted band size: |
47 kDa |
|
WB Positive control: |
293T and K562 cells, human fetal kidney tissue |
|
WB Recommended dilution: |
500-2000 |


 購物車
購物車 幫助
幫助
 021-54845833/15800441009
021-54845833/15800441009